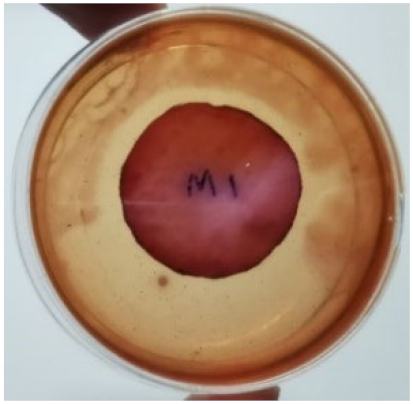
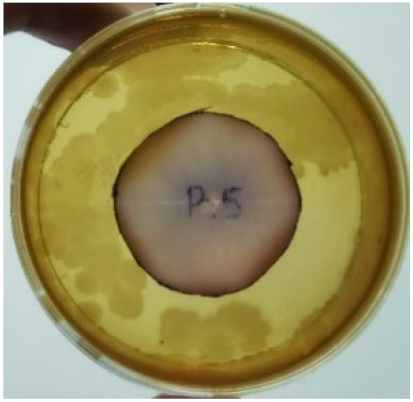
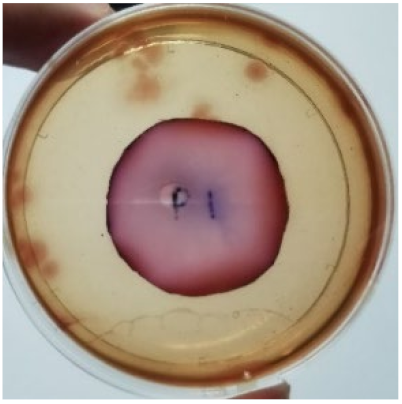
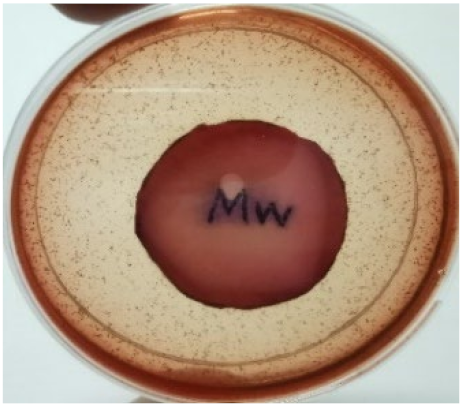
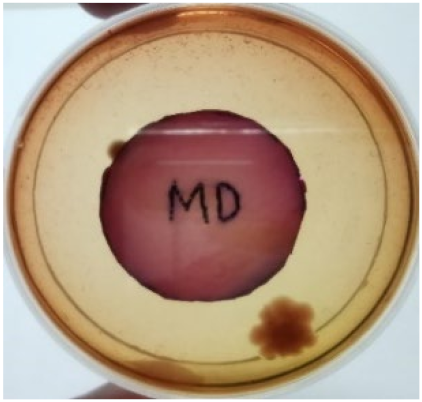
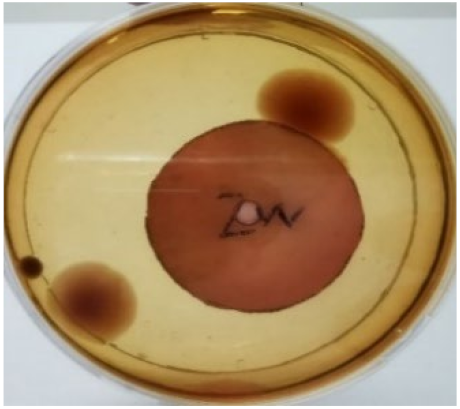
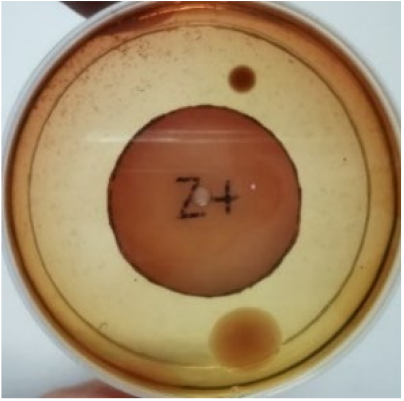
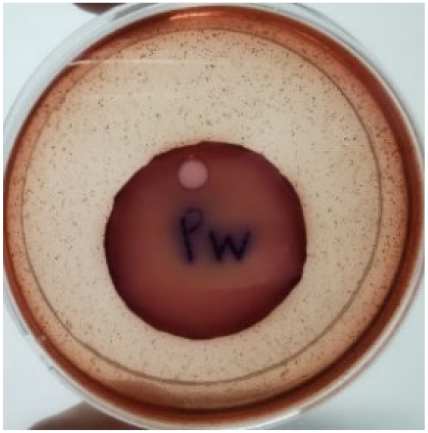

Natural Rubber (NR) Latex Films with Antimicrobial Properties for Stethoscope Diaphragm Covers
Abstract
1. Introduction
2. Materials and Methods
2.1. Materials
2.2. Preparation of Antimicrobial NR Latex Films
2.3. Post-Processing of NR Latex Film
2.4. Preparation of Bacteria
2.5. Characterisation of Antimicrobial Latex Film
2.5.1. Antimicrobial Test
2.5.2. Tensile Test
2.5.3. Tear Test
2.5.4. Swelling Test
- Wi = initial weight of test piece;
- Ws = swollen weight of test piece.
2.5.5. Crosslink Density
- Wa = weight of swollen latex sample after toluene immersion;
- Wb = weight of unswollen latex sample after drying;
- ρ1 = density of the latex samples;
- ρ2 = density of toluene (0.867 g/cm3) [44].
- χ = interaction parameter for the rubber−toluene system (0.39);
- Vr = The volume fraction of the latex films in swollen state;
- Vs = Molecular volume of toluene (106.2 cm3/mol).
3. Results
3.1. Effect of Antimicrobial Agent Loading on Antimicrobial Activity of NR Latex Films
3.2. Effect of Antimicrobial Agent Loading on Mechanical Properties of NR Latex Films
3.3. Swelling Index and Crosslink Density
3.4. Effect of Leaching and Accelerated Ageing on Antimicrobial Activity of NR Latex Films
3.5. Effect of Leaching and Accelerated Ageing on Mechanical Properties of NR Latex Films
4. Conclusions
Author Contributions
Funding
Data Availability Statement
Acknowledgments
Conflicts of Interest
References
- Sengupta, S.; Sirkar, A.; Shivananda, P.G. Stethoscopes and nosocomial infection. Indian J. Pediatrics 2000, 67, 197–199. Available online: https://link.springer.com/article/10.1007/BF02723663?msclkid=2b88a55ad01711eca5ad42d78a7fd3b0#citeas (accessed on 31 March 2022). [CrossRef] [PubMed]
- Tietze, K.J. Chapter 4—Physical Assessment Skills. In Clinical Skills for Pharmacists, 3rd ed.; Mosby: Maryland Heights, MO, USA, 2011; Available online: https://www.elsevier.com/books/clinical-skills-for-pharmacists/tietze/978-0-323-07738-5 (accessed on 10 March 2022).
- Horiuchi, Y.; Wettersten, N.; Vasudevan, R.S.; Barnett, O.; Maisel, A.S. Stethoscope as a Vector for Infectious Disease. Curr. Emerg. Hosp. Med. Rep. 2018, 6, 120–125. Available online: https://link.springer.com/article/10.1007/s40138-018-0167-4 (accessed on 10 March 2022). [CrossRef]
- Hong, S.; Bunge, J.; Leslin, C.; Jeon, S.; Epstein, S.S. Polymerase chain reaction primers miss half of rRNA microbial diversity. ISME J. 2009, 3, 1365–1373. [Google Scholar] [CrossRef] [PubMed]
- Bansal, A.; Sarath, R.S.; Bhan, B.D.; Gupta, K.; Purwar, S. To assess the stethoscope cleaning practices, microbial load and efficacy of cleaning stethoscopes with alcohol-based disinfectant in a tertiary care hospital. J. Infect. Prev. 2019, 20, 46–50. [Google Scholar] [CrossRef]
- Bukharie, H.A.; Al-Zahrani, H.; Rubaish, A.M.; Abdulmohsen, M.F. Bacterial contamination of stethoscopes. J. Fam. Community Med. 2004, 11, 31–33. Available online: https://pubmed.ncbi.nlm.nih.gov/23012043/ (accessed on 31 March 2022).
- O’Flaherty, N.; Fenelon, L. The stethoscope and healthcare-associated infection: A snake in the grass or innocent bystander? J. Hosp. Infect. 2015, 91, 1–7. [Google Scholar] [CrossRef]
- Peacock, W.F.; Kalra, S.; Vasudevan, R.S.; Torriani, F. Aseptic Stethoscope Barriers Prevent C difficile Transmission In Vitro. Mayo Clin. Proc. Innov. Qual. 2021, 5, 103–108. [Google Scholar] [CrossRef]
- Wood, M.; Lund, R.; Stevenson, K. Bacterial contamination of stethoscopes with antimicrobial diaphragm covers. Am. J. Infect. Control 2007, 35, 263–266. [Google Scholar] [CrossRef]
- Muniz, J.; Sethi, R.K.V.; Zaghi, J.; Ziniel, S.I.; Sandora, T.J. Predictors of stethoscope disinfection among pediatric health care providers. Am. J. Infect. Control 2012, 40, 922–925. [Google Scholar] [CrossRef]
- Scarano, A.; Inchingolo, F.; Lorusso, F. Environmental Disinfection of a Dental Clinic during the COVID-19 Pandemic: A Narrative Insight. BioMed Res. Int. 2020, 2020, 8896812. [Google Scholar] [CrossRef]
- Patel, L.; Gandhi, D.; Beddow, D. Controversies on the Stethoscope During COVID-19: A Necessary Tool or an Unnecessary Evil? Am. J. Med. Sci. 2021, 361, 278–280. [Google Scholar] [CrossRef] [PubMed]
- Sahiledengle, B.; Tekalegn, Y.; Bekele, K.; Tesemma, A.; Quisido, B.J.E. Disinfection of Stethoscope and Non-Infrared Thermometer: Practices of Physicians in Ethiopia in the Era of COVID-19. Risk Manag. Healthc. Policy 2020, 13, 3245–3257. [Google Scholar] [CrossRef] [PubMed]
- Kalra, S.; Amin, A.; Albert, N.; Cadwell, C.; Edmonson, C.; Gaynes, R.; Hand, M.; Marinella, M.; Morely, C.; Sieck, S.; et al. Stethoscope hygiene: A call to action. Recommendations to update the CDC guidelines. Infect. Control Hosp. Epidemiol. 2021, 42, 740–742. [Google Scholar] [CrossRef]
- Syuhada, D.N.; Azura, A.R. Waste Natural Polymers as Potential Fillers for Biodegradable Latex-Based Composites: A Review. Polymers 2021, 13, 3600. [Google Scholar] [CrossRef] [PubMed]
- Huda, N.; Mohd, A.-H. Leaching A Critical Factor in processing of rubber examination gloves. Malays. Rubber Technol. Dev. 2014, 1, 16–21. Available online: https://www.researchgate.net/publication/324079984_Leaching_A_Critical_Factor_in_processing_of_rubber_examination_gloves (accessed on 31 March 2022).
- Norhazariah, S.; Azura, A.R.; Sivakumar, R.; Azahari, B. Effect of Different Preparation Methods on Crosslink density and Mechanical Properties of Carrageenan filled Natural Rubber (NR) Latex Films. Procedia Chem. 2016, 19, 986–992. [Google Scholar] [CrossRef][Green Version]
- Rahman, M.F.A.; Rusli, A.; Kuwn, M.T.; Azura, A.R. Effect of Latex Compound Dwell Time for the Production of Prototyped Biodegradable Natural Rubber Latex Gloves. IOP Conf. Ser. Mater. Sci. Eng. 2019, 548, 012017. Available online: https://iopscience.iop.org/article/10.1088/1757-899X/796/1/012017/pdf (accessed on 31 March 2022). [CrossRef]
- Burnett-Boothroyd, S.C.; McCarthy, B.J. 13—Antimicrobial treatments of textiles for hygiene and infection control applications: An industrial perspective. In Textiles for Hygiene and Infection Control; Woodhead Publishing: Cambridge, UK, 2011. [Google Scholar] [CrossRef]
- Zhang, N.; Cao, H. Enhancement of the Antibacterial Activity of Natural Rubber Latex Foam by Blending It with Chitin. Materials 2020, 13, 1039. [Google Scholar] [CrossRef]
- Moopayak, W.; Tangboriboon, N. Mangosteen peel and seed as antimicrobial and drug delivery in rubber products. J. Appl. Polym. Sci. 2020, 137, 49119. [Google Scholar] [CrossRef]
- Moopayuk, W.; Tangboriboon, N. Anti-Microbial and Self-Cleaning of Natural Rubber Latex Gloves by Adding Mangosteen Peel Powder. Key Eng. Mater. 2018, 777, 3–7. [Google Scholar] [CrossRef]
- Anand, K.; Varghese, S.; Kurian, T. Effect of Micro and Nano Zinc Oxide on the Properties of Pre-Vulcanized Natural Rubber Latex Films. Prog. Rubber Plast. Recycl. Technol. 2015, 31, 145–156. [Google Scholar] [CrossRef]
- Anand, K.; Varghese, S.; Kurian, T. Effect of nanoparticulate Zinc Oxide on the Properties of natural Rubber Vulcanizates produced by Latex Compounding. KGK Kaut Gummi Kunst 2017, 70, 34–39. Available online: https://www.kgk-rubberpoint.de/wp-content/uploads/2017/02/KGK_1-2_2017_34-39.pdf (accessed on 31 March 2022).
- Mam, K.; Dangtungee, R. Effects of silver nanoparticles on physical and antibacterial properties of natural rubber latex foam. Mater. Today Proc. 2019, 17, 1914–1920. [Google Scholar] [CrossRef]
- Lee, S.Y.; Ng, A.; Jaswan Singh, M.S.; Liew, Y.K.; Gan, S.N.; Koh, R.Y. Physicochemical and antimicrobial properties of natural rubber latex films in the presence of vegetable oil microemulsions. J. Appl. Polym. Sci. 2017, 134. [Google Scholar] [CrossRef]
- Lepelletier, D.; Maillard, J.Y.; Pozzetto, B.; Simon, A. Povidone Iodine: Properties, Mechanisms of Action, and Role in Infection Control and Staphylococcus aureus Decolonization. Antimicrob. Agents Chemother. 2020, 64, e00682-20. [Google Scholar] [CrossRef] [PubMed]
- Ghosh, S.; Remanan, S.; Mondal, S.; Ganguly, S.; Das, P.; Singha, N.; Das, N.C. An approach to prepare mechanically robust full IPN strengthened conductive cotton fabric for high strain tolerant electromagnetic interference shielding. Chem. Eng. J. 2018, 344, 138–154. [Google Scholar] [CrossRef]
- Han, J.-W.; Jeon, J.-H.; Park, C.-G. Mechanical and Permeability Characteristics of Latex-Modified Pre-Packed Pavement Repair Concrete as a Function of the Rapid-Set Binder Content. Materials 2015, 8, 6728–6737. [Google Scholar] [CrossRef]
- Byappanahalli, M.N.; Roll, B.M.; Fujioka, R.S.J.M. Evidence for occurrence, persistence, and growth potential of Escherichia coli and enterococci in Hawaii’s soil environments. Microbes Environ. 2009, 27, 164–170. [Google Scholar] [CrossRef]
- Byappanahalli, M.; Fujioka, R. Indigenous soil bacteria and low moisture may limit but allow faecal bacteria to multiply and become a minor population in tropical soils. Water Sci. Technol. 2004, 50, 27–32. Available online: https://pubmed.ncbi.nlm.nih.gov/15318482/ (accessed on 31 March 2022). [CrossRef]
- Goto, D.K.; Yan, T. Effects of Land Uses on Fecal Indicator Bacteria in the Water and Soil of a Tropical Watershed. Microbes Environ. 2011, 26, 254–260. [Google Scholar] [CrossRef]
- Mankin, K.; Wang, L.; Hutchinson, S.; Marchin, G.L. Escherichia coli sorption to sand and silt loam soil. Trans. ASABE 2007, 50, 1159–1165. Available online: https://elibrary.asabe.org/abstract.asp??JID=3&AID=23630 (accessed on 31 March 2022). [CrossRef]
- Van Elsas, J.D.; Semenov, A.V.; Costa, R.; Trevors, J.T. Survival of Escherichia coli in the environment: Fundamental and public health aspects. ISME J. 2011, 5, 173–183. [Google Scholar] [CrossRef] [PubMed]
- Al-Saleh, E.; Akbar, A. Occurrence of Pseudomonas aeruginosa in Kuwait soil. Chemosphere 2015, 120, 100–107. [Google Scholar] [CrossRef] [PubMed]
- Crone, S.; Vives-Flórez, M.; Kvich, L.; Saunders, A.M.; Malone, M.; Nicolaisen, M.H.; Martínez-García, E.; Rojas-Acosta, C.; Catalina Gomez-Puerto, M.; Calum, H.; et al. The environmental occurrence of Pseudomonas aeruginosa. APMIS 2020, 128, 220–231. [Google Scholar] [CrossRef]
- Green, S.K.; Schroth, M.N.; Cho, J.J.; Kominos, S.D.; Vitanza-Jack, V.B. Agricultural Plants and Soil as a Reservoir for Pseudomonas aeruginosa. Appl. Microbiol. 1974, 28, 987–991. [Google Scholar] [CrossRef]
- Byappanahalli, M.N.; Nevers, M.B.; Korajkic, A.; Staley, Z.R.; Harwood, V.J. Enterococci in the Environment. Microbiol. Mol. Biol. Rev. 2012, 76, 685–706. [Google Scholar] [CrossRef]
- Frentrup, M.; Thiel, N.; Junker, V.; Behrens, W.; Münch, S.; Siller, P.; Kabelitz, T.; Faust, M.; Indra, A.; Baumgartner, S.; et al. Agricultural fertilization with poultry manure results in persistent environmental contamination with the pathogen Clostridioides difficile. Environ. Microbiol. 2021, 23, 7591–7602. [Google Scholar] [CrossRef]
- Turner, N.A.; Smith, B.A.; Lewis, S.S. Novel and emerging sources of Clostridioides difficile infection. PLoS Pathog. 2019, 15, e1008125. [Google Scholar] [CrossRef]
- Simango, C.; Mwakurudza, S. Clostridium difficile in broiler chickens sold at market places in Zimbabwe and their antimicrobial susceptibility. Int. J. Food Microbiol. 2008, 124, 268–270. [Google Scholar] [CrossRef]
- Simango, C. Prevalence of Clostridium difficile in the environment in a rural community in Zimbabwe. Trans. R. Soc. Trop. Med. Hyg. 2006, 100, 1146–1150. [Google Scholar] [CrossRef]
- Berger, F.K.; Mellmann, A.; Bischoff, M.; von Müller, L.; Becker, S.L.; Simango, C.; Gärtner, B. Molecular epidemiology and antimicrobial resistance of Clostridioides difficile detected in chicken, soil and human samples from Zimbabwe. Int. J. Infect. Dis. 2020, 96, 82–87. [Google Scholar] [CrossRef] [PubMed]
- Jing, C.; Lei, Y.; Jieping, Z.; Sidong, L.; Yongjun, C.; Kui, X. Drying kinetics and cross-linking of sulfur prevulcanized thick natural rubber latex film. Rubber Chem. Technol. 2013, 86, 57–67. [Google Scholar] [CrossRef]
- Balouiri, M.; Sadiki, M.; Ibnsouda, S.K. Methods for in vitro evaluating antimicrobial activity: A review. J. Pharm. Anal. 2016, 6, 71–79. [Google Scholar] [CrossRef] [PubMed]
- Chaiwarit, T.; Kantrong, N.; Sommano, S.R.; Rachtanapun, P.; Junmahasathien, T.; Kumpugdee-Vollrath, M.; Jantrawut, P. Extraction of Tropical Fruit Peels and Development of HPMC Film Containing the Extracts as an Active Antibacterial Packaging Material. Molecules 2021, 26, 2265. [Google Scholar] [CrossRef]
- Eggers, M. Infectious Disease Management and Control with Povidone Iodine. Infect. Dis. Ther. 2019, 8, 581–593. [Google Scholar] [CrossRef] [PubMed]
- Mudunkotuwa, I.A.; Rupasinghe, T.; Wu, C.-M.; Grassian, V.H. Dissolution of ZnO nanoparticles at circumneutral pH: A study of size effects in the presence and absence of citric acid. Langmuir 2012, 28, 396–403. [Google Scholar] [CrossRef]
- Roslim, R.; Tan, K.S.; Jefri, J. Study on Morphological Structures and Mechanical Properties of Natural Rubber Latex Films Prepared at Different Prevulcanisation and Drying Temperatures. J. Rubber Res. 2018, 21, 1–16. [Google Scholar] [CrossRef]
- Maciejewska, M.; Zaborski, M. The effect of zinc oxide nanoparticle morphology on activity in crosslinking of carboxylated nitrile elastomer. Express Polym. Lett. 2009, 3, 542–552. [Google Scholar] [CrossRef]
- Predeep, P.; Najidha, S. Iodine doping of prevulcanized natural rubber latex and its effect on dynamical mechanical properties. Rubber Chem. Technol. 2011, 84, 474–481. [Google Scholar] [CrossRef]
- Suttirak, W.; Manurakchinakorn, S. In vitro antioxidant properties of mangosteen peel extract. J. Food Sci. Technol. 2014, 51, 3546–3558. [Google Scholar] [CrossRef]





| Ingredients | Composition (Dry Weight phr) | |||
|---|---|---|---|---|
| C | M | Z | P | |
| 60.80% NR latex | 100 | 100 | 100 | 100 |
| 10.00% KOH | 0.8 | 0.8 | 0.8 | 0.8 |
| 20.00% potassium laurate | 0.4 | 0.4 | 0.4 | 0.4 |
| 50.80% ZnO (in micro-size) | 1 | 1 | - | 1 |
| 53.80% ZDEC | 1 | 1 | 1 | 1 |
| 54.00% sulphur | 2 | 2 | 2 | 2 |
| 56.55% antioxidant | 1 | 1 | 1 | 1 |
| 50.00% mangosteen peel powder * | - | 0.5 | - | - |
| 10.00% povidone-iodine * | - | - | - | 0.5 |
| 5.80% ZnO (in nano-size) * | - | - | 0.5 | - |
| Total | 106.2 | 106.7 | 105.7 | 106.7 |
| Antimicrobial Agent | 0.5 phr | 1.0 phr | 2.0 phr |
|---|---|---|---|
| MPP | ![]() | ![]() | ![]() |
| ZnO NP | ![]() | ![]() | ![]() |
| PVP-I | ![]() | ![]() | ![]() |
| Antimicrobial Agent Loading | Control | MPP-Filled | ZnO NP-Filled | PVP-I-Filled | ||||
|---|---|---|---|---|---|---|---|---|
| Tensile (MPa) | Tear (N/mm) | Tensile (MPa) | Tear (N/mm) | Tensile (MPa) | Tear (N/mm) | Tensile (MPa) | Tear (N/mm) | |
| 0.0 | 27.58 | 39.74 | - | - | - | - | - | - |
| 0.5 | - | - | 29.64 | 47.24 | 31.18 | 43.94 | 27.84 | 46.68 |
| 1.0 | - | - | 27.54 | 47.19 | 31.24 | 43.22 | 30.38 | 46.46 |
| 2.0 | - | - | 25.53 | 47.51 | 30.85 | 43.34 | 31.46 | 46.33 |
| Antimicrobial Agent | Wet-Gel | Dry-Gel | Wet and Dry Gel |
|---|---|---|---|
| MPP | ![]() | ![]() | ![]() |
| ZnO NP | ![]() | ![]() | ![]() |
| PVP-I | ![]() | ![]() | ![]() |
| Leaching Conditions | Control | MPP-Filled | ZnO NP-Filled | PVP-I-Filled | ||||
|---|---|---|---|---|---|---|---|---|
| Tensile (MPa) | Tear (N/mm) | Tensile (MPa) | Tear (N/mm) | Tensile (MPa) | Tear (N/mm) | Tensile (MPa) | Tear (N/mm) | |
| Unleached | 27.58 | 43.06 | 25.53 | 47.51 | 30.85 | 43.34 | 31.46 | 46.33 |
| Wet | 31.17 | 44.06 | 32.60 | 50.10 | 31.95 | 47.13 | 32.84 | 47.53 |
| Dry | 29.72 | 48.03 | 34.38 | 54.48 | 31.25 | 47.75 | 35.79 | 47.88 |
| Wet + Dry | 29.41 | 48.49 | 33.84 | 65.21 | 31.79 | 52.77 | 33.25 | 50.75 |
Publisher’s Note: MDPI stays neutral with regard to jurisdictional claims in published maps and institutional affiliations. |
© 2022 by the authors. Licensee MDPI, Basel, Switzerland. This article is an open access article distributed under the terms and conditions of the Creative Commons Attribution (CC BY) license (https://creativecommons.org/licenses/by/4.0/).
Share and Cite
Sarih, N.M.; Gwee, K.; Maher, S.; Rashid, A.A. Natural Rubber (NR) Latex Films with Antimicrobial Properties for Stethoscope Diaphragm Covers. Materials 2022, 15, 3433. https://doi.org/10.3390/ma15103433
Sarih NM, Gwee K, Maher S, Rashid AA. Natural Rubber (NR) Latex Films with Antimicrobial Properties for Stethoscope Diaphragm Covers. Materials. 2022; 15(10):3433. https://doi.org/10.3390/ma15103433
Chicago/Turabian StyleSarih, Norfatirah Muhamad, Kevin Gwee, Simon Maher, and Azura A. Rashid. 2022. "Natural Rubber (NR) Latex Films with Antimicrobial Properties for Stethoscope Diaphragm Covers" Materials 15, no. 10: 3433. https://doi.org/10.3390/ma15103433
APA StyleSarih, N. M., Gwee, K., Maher, S., & Rashid, A. A. (2022). Natural Rubber (NR) Latex Films with Antimicrobial Properties for Stethoscope Diaphragm Covers. Materials, 15(10), 3433. https://doi.org/10.3390/ma15103433